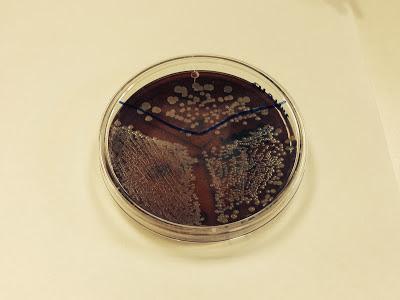
La Mastitis ¿qué es?. Mi práctica en la Universidad Complutense. La Mastitis ¿qué es?. Mi práctica en la Universidad Complutense.
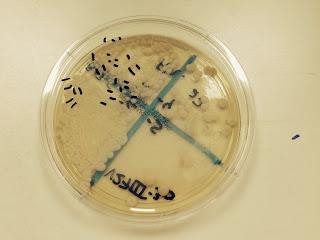
La Mastitis ¿qué es?. Mi práctica en la Universidad Complutense. La Mastitis ¿qué es?. Mi práctica en la Universidad Complutense.

Cultivo de leche materna con Staphilococos Epidermidis
La semana pasada acudí a un estupendo taller que impartían dos Microbiólogas en la Facultad de Veterinaria de la Universidad Complutense. Este taller trataba sobre las Mastitis en la mujer.Sí, habeis leído bien, EN LA FACULTAD DE VETERINARIA; Y por qué no en Enfermería o en Medicina? pues porque por lo visto era más rentable estudiar la leche de las vacas (que da mucho dinerito para Pascual, Asturiana…)que la de las mujeres, ya que ésta última no se vende y además existen estupendos sucedáneos lácteos (en los que sí se investiga) con los que alimentar a los bebés si es que su madre tiene problemas para dar el pecho.Bueno, pues resulta que hasta hace unos años, cuando una vaca lechera sufría la infección de una de sus ubres (Mastitis), se le tomaba una muestra y se analizaba para ver qué agente patógeno tenía, para así poder ponerle el tratamiento adecuado y que el dueño/empresario no perdiera dinerito.¿Qué sucedía (y aún sigue sucediendo en muchos sitios) si una mujer acudía al servicio de Urgencias de un Hospital/Centro de Salud con un pecho inflamado, dolorido, del cual a penas sale leche de lo lleno que está, con fiebre…?Pues si tiene suerte se le intentará identificar la causa pero lo más probable es que se le mande un antibiótico ¿cuál? pues… Augmentine que sirve para todo, no? y… que se saque leche con el sacaleches… y… uff, si le duele mucho que deje el pecho, no?PERO EN BASE A QUÉ SE HACEN ESTAS COSAS???? En primer lugar ¿Qué es una Mastitis?
Es la inflamación obstrucción de los conductos galactóforos (los conductos que transportan la leche hasta el pezón)En las mastitis agudas puede haber malestar general, inflamación de ganglios, fiebre…Pero en la mayoría de mastitis (crónicas y subagudas) suele haber sintomatología local en el pecho: dolor, inflamación, quemazón, pinchazos durante el amamantamiento…¿Cuáles son los principales motivos que causan las Mastitis?La Disbiosis (desequilibrio entre la microflora habitual que hay en la leche materna).Al contrario de lo que mucha gente piensa, en la leche hay bacterias y células somaticas q vienen casi siempre del tracto digestivo, así debe de ser, no infectan al bebé, todo lo contrario, le protegen colonizando su intestino de flora bacteriana.¿Y por qué se puede producir esa disbiosis? Pues principalmente por haberle administrado a la mujer antibióticos en la ultima etapa del embarazo o bien durante el parto/posparto.Otros motivos serían factores genéticos y también las Cesareas.
Las Mastitis más típicas suelen estar causadas por Staphilococos aureus que pueden llegar a producir hasta abscesos.
La sintomatología de pinchazos suele ser por Staphilococos Epidermidis y Strptococo Agalactiae.
Al contrario de lo que se ha pensado mucho tiempo las Mastitis no suelen estar causadas por Candida albicams, por lo que dar Antifúngicos a la madre no sirve de nada.¿Qué deberíamos hacer las Matronas/Medicos a las que nos consultan mujeres lactantes con Mastitis?
Animarlas a que lleven/envíen una muestra de su leche a Probisearch, primer laboratorio autorizado para diagnosticar mastitis humanas y otras alteraciones en lactancia.Allí le harán un cultivo, un antibiograma (para averiguar cual es el antibiótico que necesita), le darán el tratamiento individualizado y los lactobacilus necesarios para que su microflora vuelva a estar en equilibrio.
Imprescindible que la muestra a analizar sea por extraccion manual para que no pueda estar contaminada por sacaleches.Sí, el laboratorio está en Madrid pero reciben muestras de toda España.El precio es muy asequible, viene toda la información en la web.¿Cómo se analiza la leche materna?Tuve el privilegio, junto con unas compañeras, de realizar una práctica en el laboratorio de la facultad y os voy a comentar.
Este es el material que utilizamos
Nos dieron muestras de leche sana y de leche infectada que donaron las madres.
En este aparato mezclábamos la leche refrigerada (que como bien sabéis cuando se enfría se divide en una parte más líquida y otra más densa que es la grasa)
Aquí mi compañera Sonia pipeteando (cogiendo leche materna para introducirla en otro recipiente)
En esta placa siembro muestra de leche materna diluida a diferentes concentraciones para cuando crezca se pueda hacer el recuento de bacterias con facilidad.Las muestras se introducen en una estufa a 37ºC durante 48 horas; es una técnica muy rápida por lo que realmente a una mujer que ya lleva tiempo con una Mastitis le da igual esperar dos días más para que le den un tratamiento efectivo e individualizado en lugar que tomar "cualquier antibiótico clásico" que le prescriban en Urgencias y que en lugar de solucionar el problema lo empeora porque aumenta las resistencias y da vía libre a que otros microorganismos ocupen los lugares que los muertos dejaron.
Esta es una muestra de leche infectada por Estreptococo Agalactiae
Y esta es una muestra infectada por levaduras, en este caso es de otra parte del cuerpo ya que como he comentado antes casi en ningún caso se produce Mastitis por hongos ni aunque el bebe tenga Muguet (hongos en la lengua) ya que no se contagian. En este caso se tratarían los hongos del bebé pero habría que buscar igualmente la causa de la Mastitis en la madre.Habitualmente hay Staphilococos epidermidimis en poca cantidad en cualquier leche materna, pero cuando se encuentran más de 700UFC x ml es cuando se diagnostica la Mastitis.Para el diagnóstico de Mastitis por Streptococos viridians se necesitan más de 700 UFC x ml.Sólo la presencia de Staphilococos aureus o Corinebacterias en leche materna ya es diagnóstico de Mastitis.¿Qué hay de los probióticos y lactobacilus de los que tanto oímos hablar?Los probióticos son organismos vivos que cuando se administran en cantidades adecuadas proporcionan un beneficio para la salud de la persona que los toma.
Actúan dentro del sistema inmunológico regulándolo, si ya está dañado por el uso de antibióticos, lo equilibra; y si está en equilibrio actúa como preventivo para fortalecerlo.Actúan de forma lenta, deben tomarse de dos a tres meses para ver resultados pero los estudios científicos están evidenciando su importancia y valía.
Los lactobacillus son un tipo de probióticos.Hay que tener en cuenta que no todos tienen propiedades beneficiosas y además cada cepa actúa para una cosa completamente diferente.
Así, los lactobacillus que venden en la farmacia suelen ser practicos para problemas gastrointestinales porque están sacados del intestino.Los lactobacillus que dan en este laboratorio son específicos para las Mastitis porque son extraidos de leche materna de donaciones individuales, de mejores pertenecientes a grupos de lactancia… Éste y varios equipos más de investigación están trabajando actualmente con lactobacillus específicos para problemas como la Candidiasis, Mastitis, Estreptococo Agalactiae… Me queda dar las gracias por todo lo que aprendí esa mañana de miércoles, el propio Profesor Juan Miguel Rodríguez (principal responsable de estas investigaciones) bajó a charlar con nosotras y aclarar cuantas dudas teníamos.
En cuanto a las madres lactantes... Al contrario que con las grietas, con infección (Mastitis) no se debe poner la gota de leche en el pezón pues ello contribuye a que la infección se extienda. Tampoco dar Purelán (lanolina) ni cremas cicatrizantes. Lo mejor es el aceite de oliva o la lisina (dificil de adquirir).Las Mastitis tienen cura, dar de mamar no tiene qué doler!Consulta con tu Matrona al mínimo problema que tengas con la teta, podemos ayudarte.
